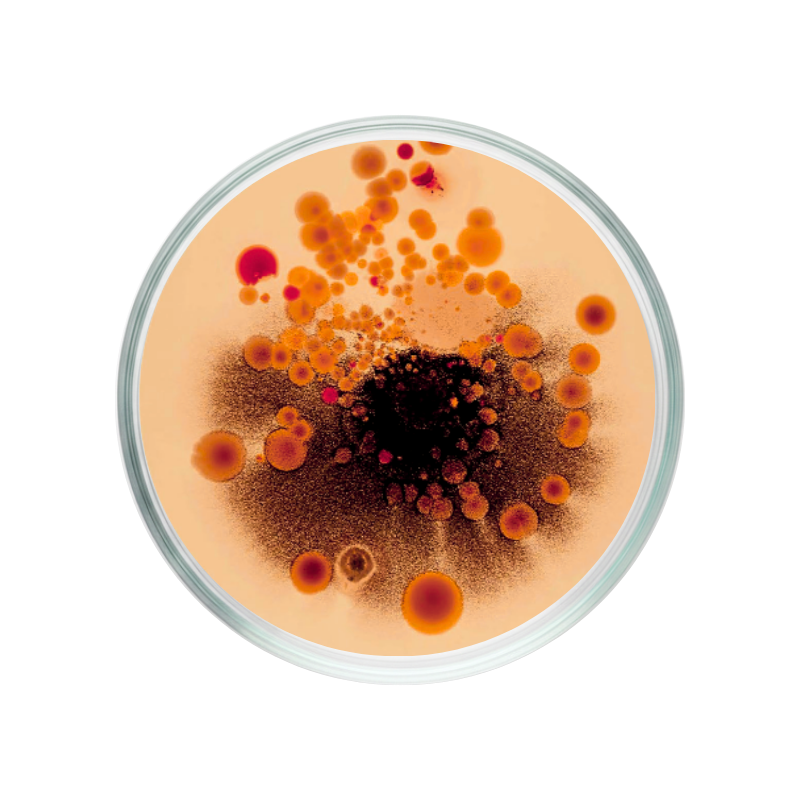

Le poivre rouge, également connu sous le nom de poivre de Cayenne ou Capsicum annuum, provient de la plante de piment chili et contient la substance capsaïcine, responsable de son piquant. Le poivre rouge contribue à la perte de poids / soutient les programmes de gestion du poids.*
Qu'est-ce que le poivre rouge ?
Le poivre rouge, également connu sous le nom de poivre de Cayenne ou Capsicum annuum, provient de la plante de piment Capsicum annuum. Originaire de l'Amérique centrale et du Sud, il est désormais cultivé dans le monde entier. Le poivre rouge est célèbre pour sa saveur piquante, qui provient de la présence de la capsaïcine.
Qu'est-ce que la capsaïcine dans le poivre rouge ?
La capsaïcine est la principale substance contenue dans le poivre rouge responsable de son piquant. Cette substance, présente principalement dans les graines et à l'intérieur du poivre, est souvent utilisée dans les compléments alimentaires. La capsaïcine est connue pour provoquer une sensation de chaleur dans le corps.
Le poivre rouge et le poivre de Cayenne sont-ils les mêmes ?
Oui, le poivre rouge et le poivre de Cayenne font référence au même assaisonnement, dérivé de la plante Capsicum annuum. Bien que les noms varient, ils partagent la même saveur et les mêmes principes actifs. Le "poivre de Cayenne" est généralement utilisé en cuisine, tandis que le "poivre rouge" est plus couramment utilisé dans les compléments alimentaires.
Le poivre rouge est-il efficace seulement si je fais attention à mon alimentation ?
L'extrait de poivre rouge peut être un complément utile dans le cadre d'un plan alimentaire sain et associé à suffisamment d'exercice. Il soutient les programmes de gestion du poids.* Pour des résultats optimaux, il est recommandé de l'associer à un mode de vie sain.
Le poivre rouge peut-il aider à la perte de poids ?
Le poivre rouge contribue à la perte de poids / soutient les programmes de gestion du poids.* L'extrait de poivre rouge est un ingrédient couramment utilisé dans les compléments alimentaires visant à aider à la perte de poids.
Puis-je prendre du poivre rouge sous forme de complément ?
L'extrait de poivre rouge a été ajouté au Insentials Fat Burner.
*Allégation de santé en attente d'approbation européenne.







